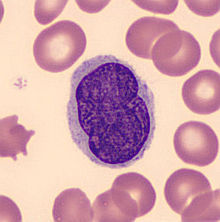
塞扎里綜合徵

病因
本病的確切病因尚不明,研究提示可能與病毒感染、環境因素、職業、遺傳及長期的基礎皮膚病變有關。臨床表現
本病好發於40~60歲男性,臨床特點為伴有劇烈瘙癢的泛發性紅皮病,常伴有水腫及大量脫屑,病期稍長者則皮膚浸潤肥厚,由於劇烈瘙癢,常伴有色素沉著,而腋窩、腹股溝等褶皺處並不受累。尚可見淺表淋巴結增大、掌跖角化過度、脫髮和甲營養不良。在紅皮病發生以前,有些患者表現為非特異性濕疹樣紅斑、脫屑,以後皮疹逐漸蔓延全身。患者白細胞計數增多,通常為(10~30)×109/L。外周血出現異常單一核細胞,即Sézary細胞。
診斷
確診需要臨床結合病理,特別是在外周血內能找到較多的Sézary細胞(一般應在10%以上),對診斷有一定意義。治療
目前尚無滿意的治療方案。早期一般採用對症治療,晚期患者考慮化療。1.局部治療
外用糖皮質激素、氮芥、卡莫司汀、維A酸,可採用光療、淺表放射治療及電子束照射治療。瘙癢是本病病人的最大痛苦,如一般方法不能控制時,電子束照射可以減輕瘙癢,全身每次照射3~4Gy,持續6周至6個月,總量達12~18Gy。
2.系統治療
常用的包括光置換療法、干擾素、單克隆抗體等免疫調節治療,也可採用化療、維A酸及組蛋白去乙醯化酶抑制劑等。化療以苯丁酸氮芥聯合糖皮質激素治療療效較佳。對頑固患者可採用甲氨蝶呤聯合干擾素聯合治療6~12個月。新合成的維A酸倍扎羅汀可單獨或與其他方法如干擾素聯合治療。還可試用HDAC抑制劑、地尼白介素、單克隆抗體等。
3.骨髓移植及幹細胞移植
有望獲得治癒,尤適用於頑固難治者。但所需費用昂貴,且併發症及高致死率限制其套用。